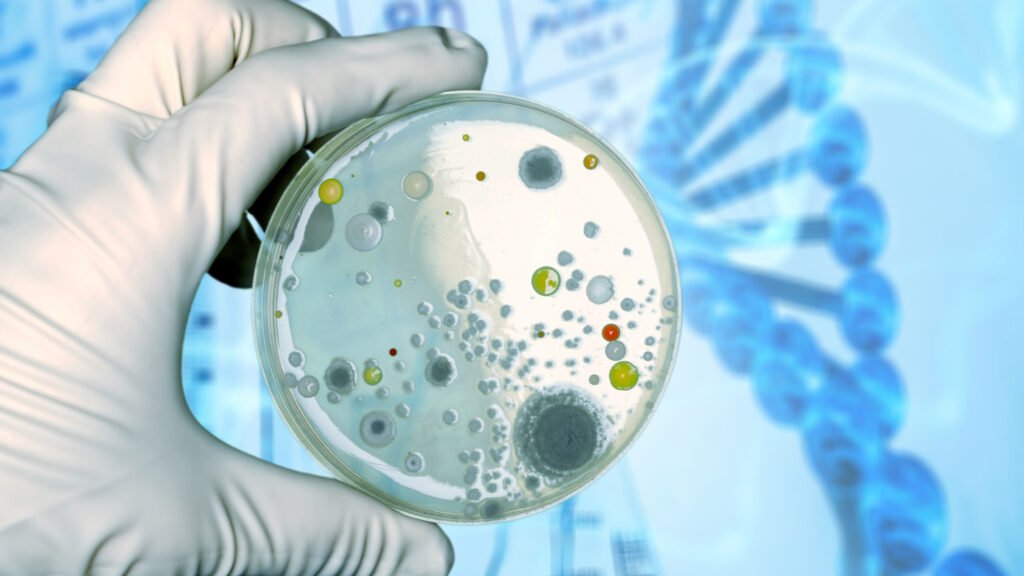

The Air Samplers come in a variety of versions with a large number of permutations allowing you to choose the spare part appropriate to your installation. The basic parts consist of a perforated head that allows air to be drawn in over the sample plate and a body (base) that incorporates the motorised impeller that draws the air in. The base is available in two mounting versions: a pedestal base for free standing locations or a Tri-Clamp base for integration within machines. The pedestal base uses a Lemo style connector for quick connection/disconnection, while the Tri-Clamp base has an integral cable.
A pre-formed cable assembly is available for the pedestal base, while the Tri-Clamp base generally requires a custom cable to be completed on-site. The head and base types must be matched and are available in two types: standard screw head and bayonet head for easier removal. A protective cover is also available which is suitable for both screw and bayonet heads. It should be noted that the flow rate itself is determined by the associated VF8023 Air Sampler controller, not the Air Sampler components.